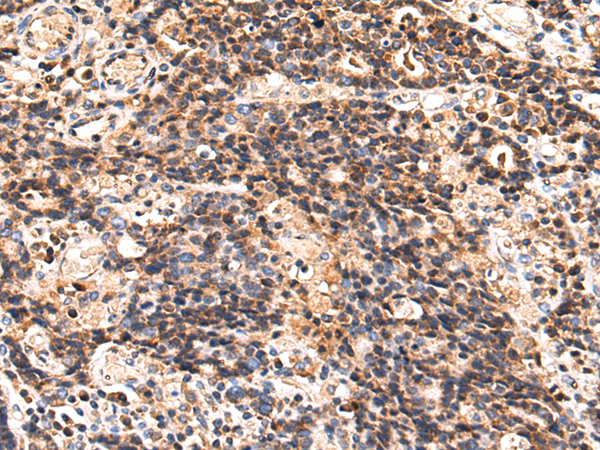
一抗

中文名稱: 兔抗MAP3K9多克隆抗體
英文名稱: Anti-MAP3K9 rabbit polyclonal antibody
別 名: mitogen-activated protein kinase kinase kinase 9; MLK1; MEKK9; PRKE1
相關(guān)類別: 一抗
儲(chǔ) 存: 冷凍(-20℃)
宿 主: Rabbit
抗 原: MAP3K9
反應(yīng)種屬: Human, Mouse
標(biāo) 記 物: Unconjugate
克隆類型: rabbit polyclonal
技術(shù)規(guī)格
|
Background: |
Serine/threonine kinase which acts as an essential component of the MAP kinase signal transduction pathway. Plays an important role in the cascades of cellular responses evoked by changes in the environment. Once activated, acts as an upstream activator of the MKK/JNK signal transduction cascade through the phosphorylation of MAP2K4/MKK4 and MAP2K7/MKK7 which in turn activate the JNKs. The MKK/JNK signaling pathway regulates stress response via activator protein-1 (JUN) and GATA4 transcription factors. Plays also a role in mitochondrial death signaling pathway, including the release cytochrome c, leading to apoptosis. |
|
Applications: |
ELISA, IHC |
|
Name of antibody: |
MAP3K9 |
|
Immunogen: |
Fusion protein of human MAP3K9 |
|
Full name: |
mitogen-activated protein kinase kinase kinase 9 |
|
Synonyms: |
MLK1; MEKK9; PRKE1 |
|
SwissProt: |
P80192 |
|
ELISA Recommended dilution: |
5000-10000 |
|
IHC positive control: |
Human prostate cancer and Human gastric cancer |
|
IHC Recommend dilution: |
50-100 |


 購(gòu)物車
購(gòu)物車 幫助
幫助
 021-54845833/15800441009
021-54845833/15800441009